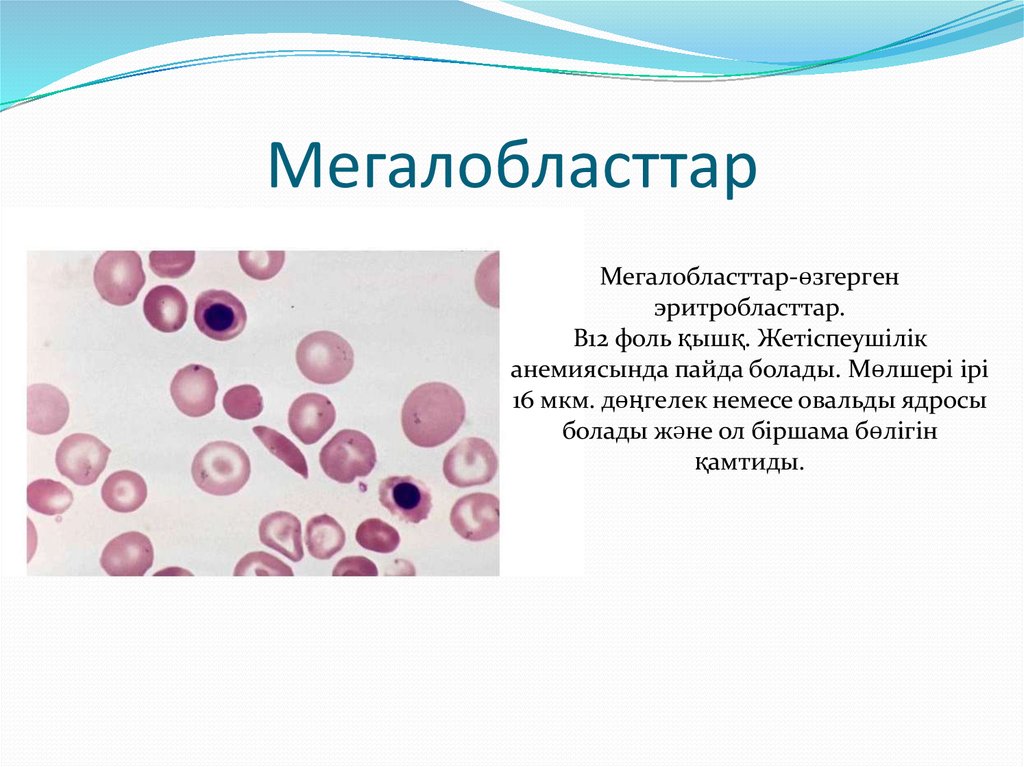
Мегалобласттар

Similar presentations:
Эритроцит патологиясы. Анемиялар
1. Қ.А.ЯСАУИ АТЫНДАҒЫ ХАЛЫҚАРАЛЫҚ ҚАЗАҚ-ТҮРІК УНИВЕРСИТЕТІ
СӨЖТақырыбы: Эритроцит патологиясы. Анемиялар.
Орындаған: Әмір А.
Қабылдаған: Исаев Н.
Тобы: ЖМ-302
Түркістан-2017
2. Жоспар
КіріспеНегізгі бөлім
Эритроцит патологиялары
Анемиялар
Зерттеу жолдары
Қорытынды
Пайдаланылған әдебиеттер
3. Кіріспе
4.
o Газ алмасуға қатысу;o Гемостазға қатысу;
o Қышқыл-сілтіл балансына
қатысу;
o Ферментативті реакцияларға
қатысу;
o Плазманың иондық балансына
қатысу.
5. Эритроцит санын анықтау(RBC)
АнықтауҚолмен;
Автоматты
есептеуіш
құралдар
арқылы;
6.
7.
8.
9.
10. Нәтижені интерпретациялау
Нормада: 4,0-5,5*10\12/л ерлерде;3,5-4,5*10\12/л әйелдерде;
Төмендеген болса(эритроцитопения): анемия, қан кету
белгілері;
Жоғары болса(эритроцитоз): эритремия.
11. Морфолгогиясын зерттеу
12.
13.
Мөлшері14. Пішінінің өзгерісі
15.
Түсінің өзгерісігипохромия
гиперхромия
полихроматофилия
16.
полихроматофилия17. Тағы қандай патологияны кездестіруге болады?
Нормобласттар- эритроциталды жасушалар.
Микроскопияда ерекшелігі
ядросы болуы, үлкен және
түсінде.
Қанда пайда болуы сүйек
қызыл кемігін
“тітіркендіргенін”
белгісі(ісік, гемолитикалық
анемияда).
18. Мегалобласттар
Мегалобласттар-өзгергенэритробласттар.
В12 фоль қышқ. Жетіспеушілік
анемиясында пайда болады. Мөлшері ірі
16 мкм. дөңгелек немесе овальды ядросы
болады және ол біршама бөлігін
қамтиды.
19. Жолли денешіктері
Жолли денешіктеріфиолетовый-қошқылтүсті қосылыстар, олар
ядро қалдығы болып
табылады. Көкбауыр мен
В12 фоль қышқ.
жетіспеушілік
анемиясында пайда
болады.
20. Кебот сақиналары
Кебот сақиналары-сақина тәріздіэритроцит қосалқысы. Ядро
субстанциясының қалдығы болып
табылады. В12 жет. Анемиясының
ауыр түрінде, ауыр металлдар
тұздарымен уланғанда пайда
болады.
21. Гейнц-Эрлих денешіктері
Гейнц-Эрлих денешіктері-гемоглобиндеструкциясы нәтижесінде эрит.
Мембрана бұзылысына алып келеді.
22. Эритроцит диаметрін өлшеу
23.
24.
25.
26. Түс көрсеткіші
Қалыпты жағдайда: 0,86-1,05Мақсат: анемияларды гиперхромды, нормохромды,
гипохромды деп бөлуге қажет.
27. Орташа эрит. гемоглобин саны
28. Анемиялар
Ерлерде-Hb 130 г/л төмен, Ht42%Әйелдерде-Hb 120 г/л төмен, Ht37%
29. Жіктелуі
Мөлшеріне байланыстыгипероцит
микроцит
нормоцит
30.
Гемоглобинге қануына байланыстыгиперхромды
гипохромды
нормохромды
31.
Ағымына байланыстыЖеңіл
91-119 г/л
Орташа
70-90 г/л
Ауыр
70 г/л төмен
32. Теміртапшылық анемиясы
33. Этиологиясы
34.
35.
36.
37.
38. Пайдаланылған әдебиеттер
Г.Е.Ройтберг, А.В.Струтынский-Внутренниеболезни лабораторная и инструментальная
диагностика.
Б.И.Шулутко, С.В.макаренко-Стандарты
диагностики и лечения внутренних болезней.

medicine
medicine








